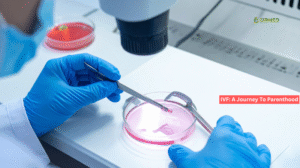

Tubal Ligation and Missed Periods – Clear Answers 2025

Tubal Ligation and Missed Periods: The Facts Every Teenager Should Understand
If you’ve recently had a tubal ligation and missed periods have you worried, take a deep breath. You’re definitely not alone in wondering about this. A tubal ligation, often called “getting your tubes tied,” is one of the most effective forms of permanent birth control available. It works by blocking or cutting the fallopian tubes, preventing an egg from traveling down to meet sperm, and therefore, preventing pregnancy.
 For many women, the surgery is a straightforward, life-changing decision that offers peace of mind. However, when your period doesn’t show up as expected afterward, it’s completely natural to panic and think, “Wait, is this possible?”
For many women, the surgery is a straightforward, life-changing decision that offers peace of mind. However, when your period doesn’t show up as expected afterward, it’s completely natural to panic and think, “Wait, is this possible?”
On your journey with EIRMED, where we focus on providing clear, supportive information on fertility and reproductive health, we want to clear up this common confusion. In this comprehensive guide, we’ll dive deep into the facts, explore the true causes of a missed period after this procedure, and explain what you should do next. Our goal is to give you such complete information that you won’t need to leave this page feeling confused.
1. Tubal Ligation (Getting Your Tubes Tied): What It Is and What It Is NOT
Tubal ligation—often called “getting your tubes tied”—is a very serious and permanent way for a woman to stop herself from getting pregnant. It is one of the most effective types of birth control.
 The Simple Job of the Fallopian Tubes
The Simple Job of the Fallopian Tubes
To understand the surgery, you need to know how pregnancy starts:
- Ovaries release an egg (this is ovulation).
- The egg travels through a tube, called the fallopian tube.
- Sperm travel up the vagina, through the uterus, and meet the egg in the fallopian tube. If they meet, the egg is fertilized, and pregnancy begins.
The Simple Goal of the Surgery
During a tubal ligation, a doctor makes a cut, ties, or puts a clip on the fallopian tubes. This blocks the path. Sperm and egg cannot meet.
The Most Important Fact: Tubal Ligation and Your Cycle
The surgery does NOT affect your hormones. Your ovaries still release hormones (estrogen and progesterone), which still cause your uterine lining to build up. When you don’t get pregnant, that lining sheds. This shedding is your period.
If you have a late or missed period after tubal ligation, the surgery itself is usually not the cause. Something else is making your cycle change.
2. Why Your Period Is Late: The Non-Pregnancy Reasons
 If you miss your period after getting your tubes tied, it’s natural to panic, but medically, doctors look at several common, non-pregnancy reasons first. (Source: Mayo Clinic, Johns Hopkins Medicine)
If you miss your period after getting your tubes tied, it’s natural to panic, but medically, doctors look at several common, non-pregnancy reasons first. (Source: Mayo Clinic, Johns Hopkins Medicine)
Cause A: Stress and Recovery After Surgery
Any operation is a major event for your body. The stress of the surgery and the recovery time can cause your body to release stress hormones.
- These hormones can temporarily confuse the signals between your brain and your ovaries.
- This confusion can delay ovulation (when the egg is released), which then pushes your whole period back. A late period is very common during the first few months of recovery.
Cause B: Stopping Hormonal Birth Control
Many women who choose tubal ligation stop using their birth control pills, patches, or shots around the same time.
- Hormone Reset: Your body needs time to “wake up” and start making its own hormones again without the medicine. This adjustment period can last three to six months.
- During this time, periods can be irregular, early, late, or even missed entirely.
Cause C: Weight and Lifestyle Changes
Major shifts in how you live can also mess with your cycle:
- Sudden changes in weight (gaining or losing a lot quickly).
- Extreme exercise (over-training) can sometimes stop your body from getting a period.
3. The One Serious Risk: Ectopic Pregnancy Signs
While tubal ligation is over 99% effective, it is not 100%. If a pregnancy does happen, there is a higher risk that it could be ectopic. (Source: WebMD, Cleveland Clinic)
Action Step: If your period is late, always take a home pregnancy test first to rule out this rare but serious possibility.
4. Tubal Ligation and Long-Term Menstrual Changes (The Myth)
Many older studies confused natural changes with the effects of the surgery. Modern research provides a clearer picture.
Myth vs. Reality
- Myth: Tubal ligation causes early menopause.
- Reality: False. The surgery does not touch your ovaries and does not change when your body naturally runs out of eggs. It does not cause menopause.
- Myth: Tubal ligation causes heavier or more painful periods.
- Reality: Some women report this (Post-Tubal Sterilization Syndrome), but major scientific studies often show no significant difference in bleeding or pain between women who have had the surgery and those who haven’t. If your period is heavier, it is likely due to aging or other conditions (like fibroids), not the sterilization itself. (Source: ResearchGate, Cleveland Clinic)
5. Next Steps: When to Call Your Doctor
You don’t need to call your doctor for a single late period, especially if the pregnancy test is negative and you’re feeling fine. However, you must seek medical advice right away if you experience any of the following. (Source: Johns Hopkins Medicine)
- A Positive Pregnancy Test: See your doctor right away to confirm the location of the pregnancy (to rule out ectopic risk).
- Missing a Second Period: If it has been over 90 days (three months) since your last period.
- Symptoms of Ectopic Pregnancy: Severe, lasting abdominal or pelvic pain, unexpected shoulder pain, or feeling extremely dizzy or faint.
- Signs of Infection/Complication (Rare): Fever above (), severe vomiting, or redness/pus coming from the surgical cut.
6. If You Want to Get Pregnant Again: IVF is the Best Option
Because tubal ligation is meant to be permanent, reversing the surgery is often difficult and not very successful.
Because tubal ligation is meant to be permanent, reversing the surgery is often difficult and not very successful.
- Many fertility specialists suggest In Vitro Fertilization (IVF) as the best choice for women who change their minds. (Source: Illume Fertility, Cleveland Clinic)
- IVF works by collecting the eggs from your ovaries, fertilizing them in a lab, and placing the resulting embryo directly into your uterus. This process completely bypasses the blocked fallopian tubes.
When to Worry: Spotting the Warning Signs
If you are experiencing tubal ligation and missed periods, your first step should always be to take a home pregnancy test. Even though the odds are strongly in your favor, ruling out pregnancy is essential.
After you’ve taken the test, here is a simple guide on what your symptoms might mean:
The Link Between Tubal Ligation and Perimenopause
Though the procedure doesn’t affect your hormones, some studies suggest that tubal ligation might slightly alter blood flow to the ovaries in some women, potentially leading to earlier onset of perimenopause (the transition phase leading up to menopause). While not common, if you are nearing your late 40s and experience tubal ligation and missed periods along with other menopausal symptoms, discuss this with your doctor.
Fertility and Tubal Ligation: What If You Change Your Mind?
At EIRMED, we understand that life circumstances change. While tubal ligation is considered permanent, sometimes women desire to have a child later on. This is where specialized fertility treatments come into play.
- Tubal Reversal: This is a surgical procedure to reconnect the fallopian tubes. It is complex, not always successful, and depends heavily on the type of ligation originally performed.
- In Vitro Fertilization (IVF): This is the most common and often most successful path for women who have had a tubal ligation. With IVF, the eggs are retrieved directly from the ovaries, fertilized with sperm in a lab (bypassing the blocked tubes entirely), and then the resulting embryo is transferred directly into the uterus.
If you are considering options after a tubal ligation, EIRMED offers products and personalized support for women exploring their next steps in fertility, whether it’s through IVF or other avenues.
Suggested YouTube Video for Your Blog
This video is a medical professional answering a direct question related to your topic, offering a clear, expert perspective.
Video Link: Is it normal to skip periods after Tubal Ligation? – Dr. Shefali Tyagi
In this video, Dr. Shefali Tyagi, a specialist, directly addresses the question of whether it’s normal to skip a period after a tubal ligation, explaining that since the procedure prevents pregnancy, a missed period is likely due to other reasons, such as hormonal imbalances, weight changes, or underlying conditions like PCOS. This video is a relevant resource for your readers because it directly addresses the common concern of a missed period following sterilization from a doctor’s point of view.
FAQ | Simple Answers to Your Common Questions
Q1: Can a doctor tell if a missed period is due to stress or not?
A doctor can often tell based on a physical exam and blood tests that check your hormone levels. However, they will rule out pregnancy first and then look at common factors like stress or birth control withdrawal.
Q2: Is there a chance my period will be lighter forever after the surgery?
No, the surgery itself does not change the amount of blood you lose. If your period is suddenly lighter, it might be due to stress or other factors, but it is not a direct result of the tubes being tied.
Q3: Why did my friend get pregnant after her tubal ligation but my doctor says it’s impossible?
It’s not truly impossible, but it is extremely rare! Sometimes the tubes can heal themselves and re-open slightly over time. This is why doctors call it a permanent method, but they always give the statistic that it’s over 99% effective, not 100%.
Overall Purpose
The main goal of this easy-to-read guide is to offer you peace of mind. Experiencing tubal ligation and missed periods is a common fear, but we want you to understand that the surgery is not the cause of the missed period in almost all cases. The delay is usually temporary, caused by stress or hormonal changes from stopping birth control. Always take a pregnancy test and watch for severe pain, but know that in most situations, a little patience is all that’s needed.
Disclaimer
The information on this EIRMED page is meant only to help you learn and understand things better. It is not a substitute for seeing a real doctor. If you have any medical questions or feel sick, you must always talk to your own doctor or healthcare provider. Never use this information to decide on your own medical care. If you think you are having a serious medical emergency, please call 911 right away.
Thank You
Thank you for choosing EIRMED for clear, honest, and supportive information. We hope this comprehensive breakdown has given you the confidence and answers you need about your health.

Eirmed is an informational platform dedicated to providing reliable, science-based insights on male and female fertility, reproductive health, and natural conception.

